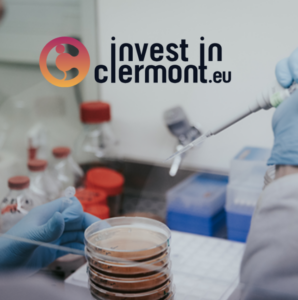

Un article qui revient sur notre mission : accompagner les marques dans l’évaluation de l’impact de leurs produits sur les microbiomes humains et sur nos perspectives autour de BYOME DERMA.

Pourquoi mesurer l’impact des produits cosmétiques sur le microbiome du cuir chevelu ?

Découvrez les réponses de Margaux, directrice Marketing chez BYOME LABS, dans cette interview par CosmeticOBS !
« Nous avons la chance d’avoir des équipes compétentes et des soutiens de taille » Margaux Jeanmougin, directrice marketing.

Notre Directrice Marketing, Margaux Jeanmougin, explique l’expertise unique de BYOME LABS dans les tests et analyses du microbiome.



Un article qui met en lumière notre mission : « En route vers la personnalisation des soins ! »

BYOME LABS remporte le prix dans la catégorie “Elles Innovent” !

Un article signé La Montagne à l’occasion de notre nomination aux Trophées des Entreprises du Puy-de-Dôme : nous avons eu l’honneur de remporter le prix dans la catégorie “Elles innovent” !
Notre site utilise des cookies pour améliorer votre expérience de navigation. En continuant à utiliser notre site, vous acceptez notre utilisation de cookies conformément à notre politique de confidentialité.